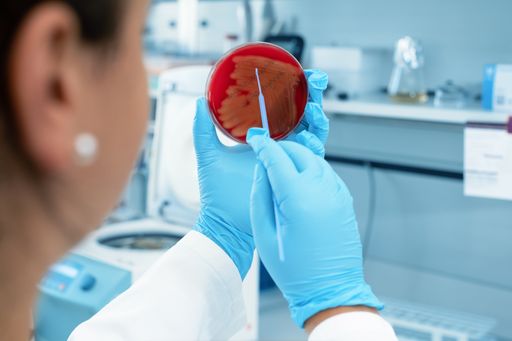
Laborarbeit / Die Verwendung dieses Bildes für redaktionelle
Zwecke ist unter Beachtung aller mitgeteilten Nutzungsbedingungen
zulässig und dann auch honorarfrei. Veröffentlichung ausschließlich
mit Bildrechte-Hinweis.

- 15.12.2022, 09:05:26
- /
- OTS0036
Artilysin®: Angstfrei in die Post-Antibiotika Zeit
Die WHO hat Antibiotikaresistenzen zu einer der 10 größten globalen Bedrohungen für die Menschheit erklärt. Um dieser Gefahr entgegenzuwirken, hat die Lysando AG die sogenannte Artilysin®-Technologie entwickelt: Neuartige antimikrobielle Proteine mit einer einzigartigen Wirkweise.
Die Artilysin®-Technologie umfasst vom Lysando-Team designte Moleküle aus flexibel kombinierbaren antibakteriellen Modulen für spezifische Anwendungen. Im Vergleich zu Antibiotika greift Artilysin® auch resistente und persistierende - also "schlafende" - Bakterienzellen effektiv an. Zudem wirkt die Technologie - beispielsweise bei topischen Anwendungen - lokal begrenzt, schwächt nicht die natürlichen Barrieren des Körpers und stört nicht das natürliche Abwehrsystem unserer Haut. Der modulare Aufbau ermöglicht ein hohes Maß an Anpassung an diverse Anwendungen und Indikationen.
Durch den speziellen Wirkmechanismus von Artilysin® werden keine Rezeptoren benötigt und schädliche Bakterienzellen innerhalb von Bruchteilen von Sekunden mechanisch eliminiert; ein Mechanismus, der die hohe Widerstandskraft gegen Resistenzen erklärt. Resistenzen gegen Antibiotika hingegen werden zunehmend bereits vor deren Markteintritt identifiziert.
"Bakterielle Infektionen stellten schon 2019 weltweit die zweithäufigste Todesursache dar - zu diesem Schluss kam eine vor kurzem veröffentlichte internationale Studie im Fachblatt The Lancet. Artilysin® ist Dank der neuartigen Wirkweise ein vielversprechender Lösungsansatz", sagt Dr. Kerstin Emmrich, Head of Research and Development der Lysando AG.
Medizinische Expertenkreise warnen seit Jahren vor dem Tag, an dem kein "Werkzeug" mehr gegen multiresistente Keime zur Verfügung steht. Artilysin® ist eine Zukunftslösung im Kampf gegen Resistenzen von bakteriellen Krankheitserregern.
Über Lysando AG
Die Lysando AG ist Marktführer für antimikrobielle Proteine, sogenannte Artilysin®e. Diese können problemverursachende Bakterien effektiv eliminieren, ohne hohes Risiko von Resistenzbildung und Dysbalancen. Artilysin®e stellen eine innovative, patentrechtlich geschützte und zudem umweltfreundliche Technologie mit mannigfaltigen Einsatzmöglichkeiten dar: einerseits in der Human- und Tiermedizin, aber zum Beispiel auch in der Kosmetikindustrie.
Die Forschungseinrichtung der Lysando AG ist die Lysando Innovations Lab GmbH mit Sitz im Regensburger BioPark. Der BioPark Regensburg fördert Unternehmen der Biotechnologie, Medizintechnik, Diagnostik & Analytik sowie die Gesundheitswirtschaft des Standorts Regensburg.
Rückfragen & Kontakt
Verena Schossmann
Tel: +41(0)79 211 83 42
E-Mail: [email protected]
OTS-ORIGINALTEXT PRESSEAUSSENDUNG UNTER AUSSCHLIESSLICHER INHALTLICHER VERANTWORTUNG DES AUSSENDERS - WWW.OTS.AT | EUN






